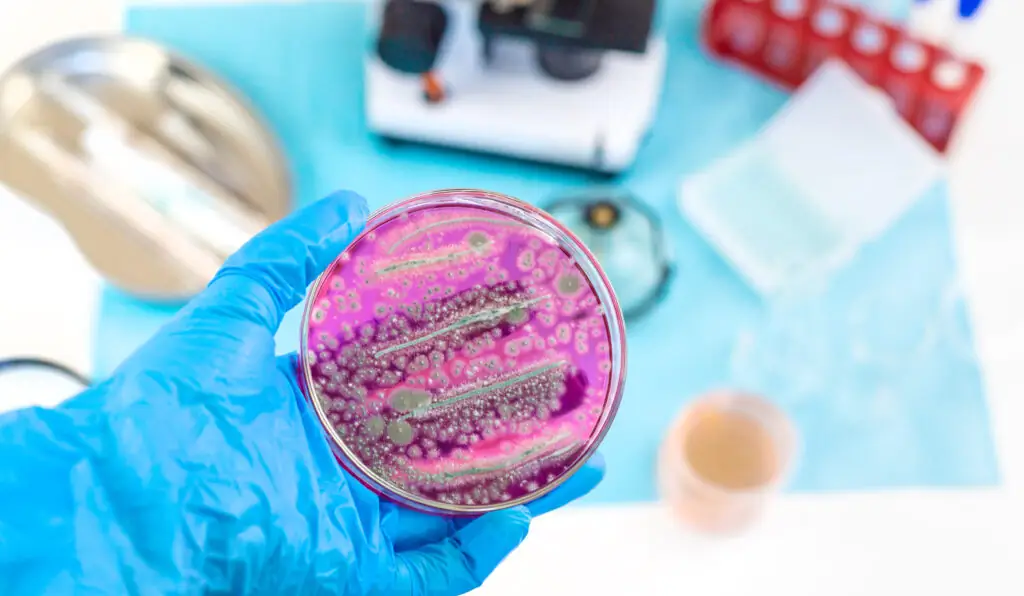
Petri dish with microbial growth held in a lab, illustrating microbiology work in the r&d pharmaceutical industry

Os microrganismos desempenham um papel fundamental na indústria farmacêutica. Funcionam simultaneamente como biofábricas para a produção de medicamentos e princípios ativos, e como ferramentas biotecnológicas que possibilitam processos mais sustentáveis, seguros e eficientes. Através deles, é possível obter antibióticos, vacinas, vitaminas, enzimas terapêuticas e uma grande variedade de compostos bioativos com elevado valor funcional.
Porque é que a microbiologia é essencial na indústria farmacêutica
A microbiologia farmacêutica engloba o conjunto de técnicas e conhecimentos associados à produção, controlo de qualidade, segurança e funcionamento dos produtos farmacêuticos, incluindo os seus mecanismos de ação.
Um domínio aprofundado de bactérias, leveduras, fungos e vírus permite:
- Produzir princípios ativos através de processos biotecnológicos como fermentação, expressão genética e cultura celular.
- Controlar contaminações e garantir a esterilidade de medicamentos injetáveis ou de uso tópico.
- Desenvolver vacinas, probióticos e terapias avançadas, incluindo terapias génica e celular.
- Reduzir a dependência de sínteses químicas poluentes, promovendo rotas biológicas mais seletivas e ambientalmente responsáveis.
Esta relevância intensificou-se com o crescimento da biotecnologia industrial, da biologia sintética e de ferramentas de edição genética como CRISPR, que permitem conceber microrganismos ajustados a necessidades industriais específicas.
Microrganismos mais eficazes na indústria farmacêutica
Diversas espécies microbianas destacam-se pela sua elevada eficiência como biofábricas para a produção de ingredientes farmacêuticos:
Escherichia coli (E. coli)
Muito utilizada para produzir proteínas recombinantes, como insulina ou fatores de crescimento. A sua manipulação genética é simples e proporciona elevados rendimentos.
Saccharomyces cerevisiae
Aplicada na produção de etanol e na expressão de proteínas terapêuticas. Representa um organismo modelo na biotecnologia industrial.
Streptomyces spp.
Bactérias do solo responsáveis pela biossíntese de antibióticos essenciais como estreptomicina, eritromicina ou tetraciclinas.
Bacillus subtilis
Utilizada na produção de enzimas e vacinas. A sua capacidade de secretar proteínas diretamente para o meio de cultura facilita o processo de purificação.
Microalgas e cianobactérias
Fontes de compostos bioativos com propriedades antioxidantes, anti-inflamatórias ou imunomoduladoras.
Fungos filamentosos (Aspergillus, Penicillium)
Essenciais na produção industrial de antibióticos, ácidos orgânicos (como o ácido cítrico) e enzimas.
I&D e inovação na indústria farmacêutica: Produção sustentável de ingredientes ativos
A sustentabilidade e a eficiência económica tornaram-se pilares da inovação na indústria farmacêutica. Atualmente, combinam-se biotecnologias avançadas com métodos de extração verde para desenvolver APIs mais limpos e com menor impacto ambiental.
Extração com CO₂ supercrítico (ALTEX)
A tecnologia ALTEX da AINIA, baseada no uso de dióxido de carbono em estado supercrítico, oferece uma solução limpa e altamente eficiente para a extração de princípios ativos:
- O CO₂ funciona como solvente reciclável e não tóxico, reduzindo o consumo de solventes orgânicos e eliminando resíduos ambientais.
- Opera a baixas temperaturas, preservando moléculas termo-sensíveis e permitindo, numa única etapa, a eliminação de pesticidas, gorduras e outros contaminantes.
- A AINIA dispõe de capacidade desde escala piloto (20 L) até escala industrial (1 000 L), cumprindo certificações ECO e Boas Práticas de Fabrico (GMP).